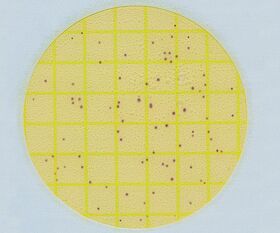

説明
【特徴】
●選択成分・栄養・冷水可溶性ゲル化剤を含む、できあがり培地です。
●プレートに含まれる指示薬でコロニーの識別を容易にします。
【仕様】
●ELプレート
●リステリア環境微生物測定用
●AOAC PTM認証取得
●<使用方法>
●▼1.拭き取りセット付属のクイックスワブで検査対象を拭き取ります。
●▼2.拭き取り溶液全液を緩衝ペプトン水に加えます。
●▼3. 1分間混ぜて均一化し、1~1.5時間放置後にELプレートに全液を接種します。
●▼4. 35±1℃または37±1℃で28時間±2時間培養し、結果を判定します。
●※保存方法:8℃以下
●★輸送条件:常温
●★旧メーカーJANコード:0707387776305
追加情報
メーカー名:
ネオジェンジャパン
メーカー品番:
6447EL
予定納期:
注文から1~3日で発送